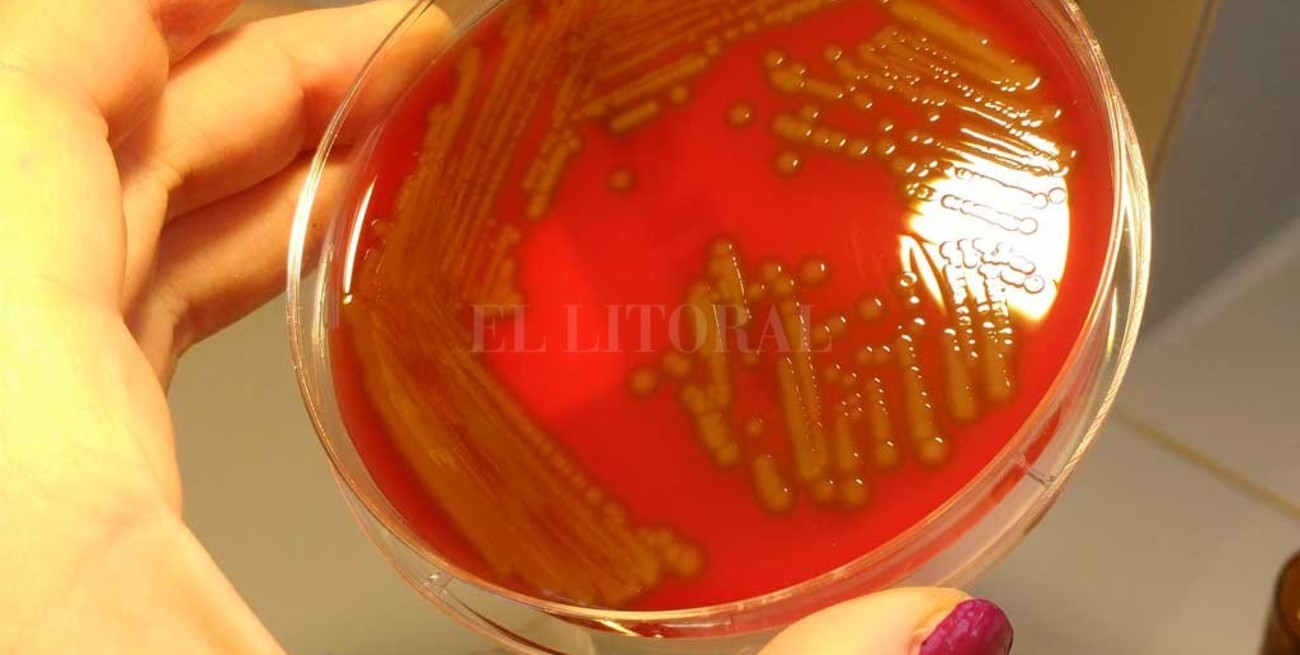

El Litoral | [email protected]
En Rosario también falleció una niña por la bacteria streptococcus pyogene
Se lo confirmaron a El Litoral desde el Ministerio de Salud de Santa Fe. El caso ocurrió en el sector privado, se está investigando y descartan que se trate de un brote. Es un germen frecuente que provoca faringitis e infecciones en la piel y en casos aislados desarrolla cuadros más graves.

La bacteria que generó las complicaciones por las que fallecieron dos niños en Buenos Aires en el Hospital Elizalde —y otros tres casos de chicos que siguen internados—, también provocó un caso fatal en la ciudad de Rosario, una niña de 6 años que murió de una sepsis (infección generalizada) en el sector privado.
Desde el Ministerio de Salud santafesino explicaron que se está investigando este último caso y descartaron que se trate de un brote. “El streptococcus pyogene es una bacteria súper frecuente y que suele dar cuadros muy leves de faringitis o de infecciones en la piel, que muy de vez en cuando terminan en cuadros más graves”, le aseguró a El Litoral Carolina Cudós, directora provincial de Epidemiología.
En la mayoría de los pacientes, la bacteria es sensible a los antibióticos y las personas se curan sin dificultades. Los cuadros más graves —que no son habituales— pueden surgir en pacientes que en forma previa tuvieron gripe, varicela o que son mayores de 65 años, inmunocomprometidos y diabéticos, entre otros grupos de riesgo.
En estos últimos pacientes, la bacteria puede generar una sepsis (infección generalizada), neumonía, peritonitis y hasta un síndrome de shock tóxico. “Algunas cepas de la bacteria tienen una toxina que cuando la liberan en sangre provoca cuadros graves. También pueden darse infecciones en la piel más graves como fascitis necrotizante, pero son cuadros más raros”, insistió Cudós.
¿Qué pueden hacer los padres para evitar riesgos? Lo más importante —según la especialista— es consultar si hay un cuadro de fiebra alta y estar muy atentos a cómo evoluciona un chico después de una faringitis (angina). “Si un niño se pone pálido, tiene fiebra alta, manchas en la piel y deterioro sensorial es fundamental consultar inmediatamente al médico”, recomendó Cudós.
También aclaró que es habitual que todos los años se reporten algunos casos graves por complicaciones con esta bacteria.